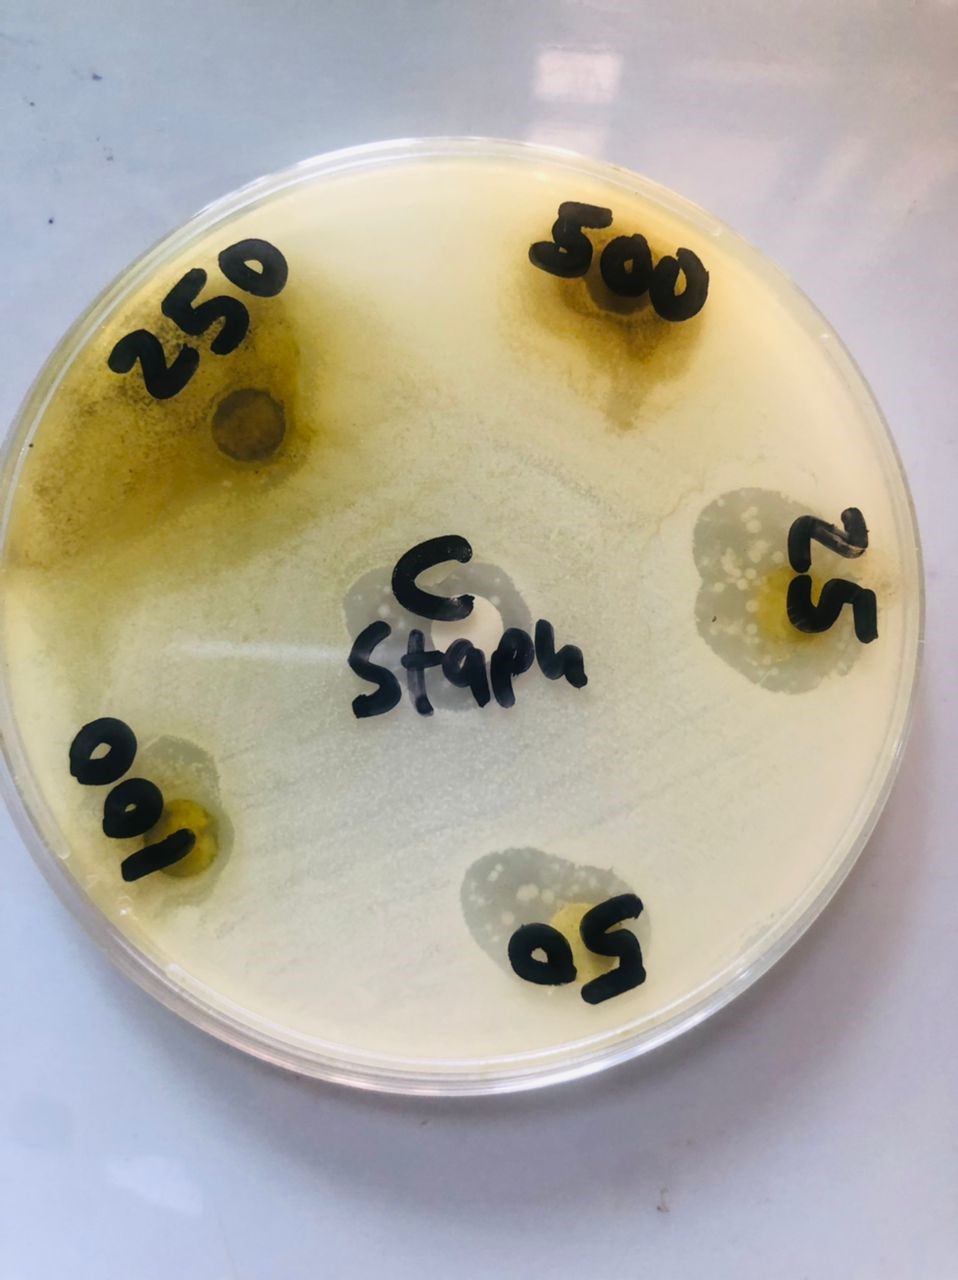

We use cookies to ensure our website works properly and to personalise your experience. Cookies policy

We use cookies to ensure our website works properly and to personalise your experience. Cookies policy
1,2,3,4,6Federal Polytechnic Ayede, Ayede, Oyo State, Nigeria
5Precious Cornerstone University, Ibadan, Oyo State, Nigeria
Jatropha curcas is used in medicine to cure various ailments in Africa. This study investigates the antibacterial potential of the n-hexane leaf extract of Jatropha curcas in comparison to standard antibiotics. Leaves were collected, air-dried, and ground into powder. One hundred and fifty grams (150g) sample were extracted with 450ml of n-hexane, and the crude extract was stored at -4?C. Phytochemical screening revealed flavonoids, terpenoids, saponins, alkaloids, tannins, and other bioactive compounds. Antibacterial activity was evaluated using the agar diffusion method against Escherichia coli, Staphylococcus aureus, Klebsiella pneumoniae, Streptococcus pneumoniae, and Salmonella typhi. The inhibition zones ranged from 7.5 mm to 31.5 mm, with the highest recorded for K. pneumoniae (31.5 mm). The extract demonstrated concentration-dependent activity, outperforming standard antibiotics in some cases. The extract exhibited a 22.5 mm inhibition zone against E. coli at 250 mg/ml, compared to 8 mm for ceftriaxone-sulbactam. Similarly, against K. pneumoniae, the extract at 500 mg/ml showed a 23 mm inhibition zone, exceeding gentamycin's 20 mm. Statistical analysis confirmed these effects as significant (p < 0.05). This study highlights the potential of Jatropha curcas as a natural antibacterial agent, offering a promising alternative to combat multidrug-resistant pathogens.
Since the advent of orthodox medicine, plants have been employed for various purposes. Leaves, fruit, flowers, stems, roots, seeds and bark are all components of herbal medicines. Certain phytochemical constituents of these plants, which have particular physiological effects on humans are what give them their therapeutic benefits. The most significant phytochemicals are phenolic compounds, alkaloids, tannins, flavonoids, and alkaloids [1]. Plant-based medications provide a number of benefits, such as affordability, effectiveness, security and lack of side effects [2]. The most systematic approach for researching the current demand for innovative therapeutically potent drugs such as antibacterial, antihepatotoxic and anticancer therapies [3] is their efficacy with little or no side effects [4].
Jatropha curcas, a flowering plant indigenous to the tropical regions of the Americas, particularly Mexico and Central America, is classified within the Euphorbiaceae family [5]. Jatropha curcas, a semi-evergreen shrub or small tree can reach a height of at least 6 meters (20 feet) [6]. It can thrive in deserts because of its ability to endure high aridity. It contains phorbol esters, which may be potentially harmful [7]. In addition, the J. curcas contains trypsin inhibitors, curcin-which is a type of lectin-phytate, and saponins [8][9]. Thus, seeds contain on average 34% oil content ranging from 27-40% [10][11] that turns them into high quality biodiesel fuel for use in conventional diesel engines. Animal feed and food can be derived from non-toxic, edible varieties [12]. Jatropha curcas is a versatile plant that has historically been employed in both human and veterinary healthcare [13]. The applications of Jatropha curcas have been extensive in the treatment of various diseases, encompassing both fungal and bacterial infections [14]. Glycosides, tannins, phytosterol, flavonoid, and triterpenoids sapogenins, which are present in the plant's various parts, such as the leaves, fruits, latex, and bark, allow it to possess a range of therapeutic characteristics [15].
MATERIALS AND METHODS
Plant material preparation and collection
Jatropha curcas leaves were collected in Ibadan, Oyo State, Nigeria. The samples were delivered immediately to the laboratory for analysis. The plant samples were shredded into pieces. It was then air-dried for two weeks before being ground into a coarse powder using a pulverizer. The fine powder obtained after sieving the pulverized material was then placed in a cool, dry location.
Extraction of plant extract
One hundred and fifty grams (150 g) of the fine powered leaves were weighed and soaked for 48 hours in 450ml of n-hexane. Following sterile muslin cloth purification, the fractions were placed in a dry, cool environment for evaporation-based concentration of the filtrates (solvent extracts). The leftover crude extracts for n-hexane were in a colloid and granular state after evaporation. For antibacterial and phytochemical testing, the raw extract was kept in the refrigerator at a temperature of -4?C.
Phytochemical Screening of Crude Extracts
The phytochemicals of crude plant extract of Jatropha curcas were investigated according to the method used by [16][17]and the procedure is explained in the steps below.
Testing for tannins
Five grams (5g) of powdered leaf samples were weighed, added to a test tube with ten millilitres of distilled water, boiled, and filtered. To create a blue-green precipitate that would act as an indicator, Iron (III) chloride (0.1%) were added to the filtered samples in drops. This confirmed that tannins were present.
Testing for flavonoids?
The magnesium strips were added in a few drops while being stirred after a 5g sample had been weighed. A yellowish colouration was noticed after adding strong hydrochloric acid, pointing to the presence of flavonoids.
Steroids?testing?
By mixing 2 ml of chloroform with 5g of a leaf sample, the presence of steroids was confirmed. Sulphuric acid was then added to the sample to further confirm the presence of steroids (a blowfish green colour at the interface).
Testing?for?saponin
Heat was applied to a test tube that contained 5g of the powdered leaf sample and 10 ml of distilled water. Foaming that persisted was used to determine the presence of saponins.
Testing for anthraquinone
A 5 g leaf sample was accurately weighed and then a 10 mL solution of benzene was added, agitated, and filtered. Thereafter, a 5mL solution of ammonia was added. After filtering, it was mixed with benzene gray. A volume of 5mL ammonia was added. Anthraquinone was confirmed to be present by the ammonia phase taking on a greenish yellow colour.
Testing for reducing sugar
A test tube was filled with 0.5 g of powdered leaf sample, 1 ml of distilled water, and 5-8 drops of Fehling's solution and placed in a water bath. The appearance of red (brick) precipitation served as evidence that there was reduced sugar present.
Testing for alkaloids
0.5g of leaf sample and 2 ml of chloroform were poured into a test tube. Following the addition of 3?4 drops of Wagner's reagent to the mixture; a reddish-brown colouring revealed the presence of alkaloids.
Testing for?terpenoids?
0.5g was combined with 3ml of saturated H2SO4 and 2 ml of chloroform (filtrate). The emergence of a reddish-brown covering served as proof that terpenoids were present.
Testing for phlobatanin
Hydrochloric acid (1%) was added to 0.5g of leaf sample. A reddish-brown colour was produced, confirming the presence of phlobatanin.
Resuscitation of microorganisms used
The Gram-negative bacterial isolates (Klebsiella pneumoniae, Escherichia coli, Pseudomonas aeruginosa) and Gram-positive isolate (Staphylococcus aureus) used in the study were all clinical isolates obtained from Oluyoro General Hospital and University College Hospital (UCH) both in Ibadan, Nigeria. The isolates were resuscitated on nutrient agar plates at 37oC for 24 hours then maintained on nutrient agar slants at -4?C.
Antimicrobial screening of the crude extract
Preparation of bacteria cultures
The agar well diffusion method was used in the assessment of antimicrobial activity of the plant. This method is achieved by using a sterile cork borer to make six wells on each of the nutrient agar plates. Then 100?l of the plant extracts at 1mgl-1 were dropped into wells and allowed to diffuse for 5 minutes. Tetracycline at 1mgml?1, was used as control. Plates were then kept to stand in the incubator for 24hours at 37?C [18]. Zones of inhibition were measured and recorded.
Preparation of inoculum using MacFarland Standard
Nutrient broth (NB) was cultured for 24 hours at 37?C and potato dextrose broth (PDB) for 48 hours at 28oC with test bacteria. To obtain 2106 CFU/ml for bacteria and 2105 spore/ml for fungus, the bacterial cultures were serially diluted and adjusted [19].
UV?Vis spectroscopy
The previously obtained suspensions were triple-read in a UV-Vis (Visible Spectrophotometer) in 1cm cuvettes of the optical path at ambient temperature. The sterile NB was used as a background for blanking. Each strain was inoculated in sterile nutrient broth using a different dilution factor (df) at wavelengths of 625 nm [20].
Antimicrobial activity
Using a swab stick, 0.1mL cell suspension from each bacterial species was introduced onto nutrient agar (NA). Each NA plate was gently drained after inoculation. Six-millimeter (6mm) filter paper discs were sterilized for two hours at 120 ?C. The surface of the inoculated NA plates was covered with sterilized discs, which were then immersed in each plant extract solution (at varying concentrations), alongside the control. For 24 hours, the NA plates were kept incubated at 37 ?C to ascertain the extract's activity. The antibacterial activity was calculated using the zone of inhibition formula and measured in diameter (mm).
Antibiotic susceptibility test on the collected bacteria
Two standard antibiotics used as positive controls for the susceptibility test were streptomycin (for Gram-negative bacteria) and gentamicin (Gram-positive bacteria). Using the Kirby Bauer method, the effect of antibiotics against both Gram positive and Gram-negative bacteria was tested [21].
Determination of the minimum inhibitory concentration???????
The modified procedures previously published by [22] were used to determine the plant extracts with the strongest antibacterial activity's minimal inhibitory concentrations (MIC) and minimum microbial concentration (MMC). The MIC of the crude extracts was determined using the broth dilution method in test tubes9ml of nutrient broth was dispense into different test tube which was covered with a plug (cotton wool + foil), these tubes were sterilized at 121oC for 15mins.using the autoclave. Tubes were allowed to cool at room temperature, it was labelled and arranged serially to correspond to the concentrations.
From the reconstituted extracts, 1ml was transferred into the first tube, 1ml was drawn from it into the second tube this continued till the 9th tube where 1ml was taken and discarded, then 0.2ml of the standardized organisms that were active was transferred into each tube, control tubes were incubated along with other reaction tubes at 37oC for 24h. Tubes were observed for turbidity and the least concentration that show no turbidity was recorded as the MIC. All samples were analyzed in triplicates and were used to calculate the MIC for plant extract that displayed the most significant antimicrobial activity with the minimum concentration.
Statistical Analysis???????????????????????????????????????????????????
The collected data were analyzed using the Graph Pad Prism 5. A two-way ANOVA test was used to assess the effect of the crude extracts at various doses. Additionally, statistical comparisons of n-hexane were performed; the extracts' general antimicrobial effects were compared with those of standard antibiotics, respectively.
RESULTS
The results of the antimicrobial activity of Jatropha curcas n-hexane extract against tested pathogenic microorganisms at different concentrations (i.e., 25 mg /ml, 50 mg/ml, 100 mg/ml, 250 mg/ml and 500 mg/ml) with respect to their zone of inhibition (mm) are shown in figures 1 to 5 below. Statistical analysis of the results was carried out and the significance level was determined at P < 0>
? ? ? ?
? ? ? ? ? ? 
? ? ? ?
Figure 1: Antibacterial activity of Jatropha curcas extract against Escherichia coli
? ? ? ?
? ? ? ? ? ? 
? ? ? ?
Figure 2: Antibacterial activity of Jatropha curcas extract against Streptococcus pneumoniae
? ? ? ?
? ? ? ? ? ? 
? ? ? ?
Figure 3: Antibacterial activity of Jatropha curcas extract against Klebsiella pneumonia
? ? ? ?
? ? ? ? ? ? 
? ? ? ?
Figure 4: Antibacterial activity of Jatropha curcas extract against Salmonella typhi
? ? ? ?
? ? ? ? ? ? 
? ? ? ?
Figure 5: Antibacterial activity of Jatropha curcas extract against Staphylococcus aureus
The result of the qualitative phytochemical analysis of Jatropha curcas crude extract is shown in table 1 below. The phytochemical components present in the n-hexane crude extract include flavonoids, terpenoids, saponins,alkaloids,?anthraquinones,?tannins,?reducing sugars, and phlobatanins while steroid is the only phytochemical component absent
Table 1: Phytochemical screening of J. curcas plant
|
Phytochemical |
N-hexane |
|
Saponins |
++ |
|
Steroids |
- |
|
Reducing sugar |
+++ |
|
Terpenoids |
++ |
|
Anthraquinones |
++ |
|
Quinone |
++ |
|
Flavonoids |
+ |
|
Phenolic content |
+ |
|
Phlobatanins |
++ |
|
Alkaloids |
++ |
|
Tannins |
+++ |
Key: present: +, Absent: -
Table 2: Comparison of N-hexane extract of Jatropha curcas against selected antibiotics drugs
|
Microorganisms |
Antibiotics discs and J. curcas extract concentrations |
N-hexane extract (mm) |
|
K. pneumoniae |
GN |
20.0 ? 0.0000 |
|
? |
C1 |
31.5 ? 0.7071*** |
|
? |
C2 |
19.5 ? 0.7071 |
|
? |
C3 |
22.0 ? 1.4142 |
|
? |
C4 |
26.0 ? 0.0000*** |
|
? |
C5 |
20.5 ? 0.7071 |
|
S. pneumoniae |
CIP |
25.0 ? 0.000 |
|
? |
C1 |
22.5 ? 0.7071 |
|
? |
C2 |
23.5 ? 0.7071 |
|
? |
C3 |
25.5 ? 0.7071* |
|
? |
C4 |
18.5 ? 0.7071 |
|
? |
C5 |
21.0 ? 1.4142 |
|
E. coli |
CRO |
8.0 ? 0.000 |
|
? |
C1 |
28.5 ? 0.7071*** |
|
? |
C2 |
15.5 ? 0.7071*** |
|
? |
C3 |
15.5 ? 0.7071*** |
|
? |
C4 |
14.5 ? 0.7071*** |
|
? |
C5 |
18.5 ? 0.7071*** |
|
S. typhi |
LBC |
25.0 ? 0.000 |
|
? |
C1 |
23.5 ? 0.7071 |
|
? |
C2 |
17.0 ? 1.4142 |
|
? |
C3 |
31.5 ? 0.7071*** |
|
? |
C4 |
28.5 ? 0.7071** |
|
? |
C5 |
22.5 ? 0.7071 |
|
S. aureus |
GN |
20.0 ? 0.0000 |
|
? |
C1 |
23.0 ? 1.4142 |
|
? |
C2 |
18.0 ? 1.4142 |
|
? |
C3 |
18.5 ? 0.7071 |
|
? |
C4 |
35.5 ? 0.7071*** |
|
? |
C5 |
24.0 ? 1.4142** |
Key: C1: 500mg/ml; C2: 250mg/ml; C3: 100mg/ml; C4: 50mg/ml; C5: 25mg/ml.
GN ? Gentamycin (10 ?g), CIP ? Ciprofloxacin (5 ?g), CRO ? Ceftriaxone sulbactarm (45 ?g), and LBC ? Levofloxacin (5 ?g). Values are expressed as mean ? standard deviation for n=2 for each concentration. Values with (*, **, ***) are significantly higher than the control at P < 0>
N-hexane extracts were compared statistically with selected antibiotics disc (gentamycin, ciprofloxacin, and levofloxacin for bacteria) shown in Table 2. The C4 n-hexane extracts (250 mg/ml) exhibited the highest zone of inhibition against pathogens when compared to the standard antibiotics disc used in this study. The results show that J. curcas leaf n-hexane extracts exhibit significant antibacterial activity against a range of common pathogenic bacteria, such as E. coli, S. aureus, S. typhi, S. pneumoniae, and K. pneumoniae. The extract produced an 18 mm zone of inhibition against K. pneumoniae at a concentration of 25mg/ml, and a 21.5mm zone of inhibition at a concentration of 50mg. A zone of inhibition was recorded against K. pneumoniae at a concentration of 100mg/ml which measured 18 mm, whereas a zone of inhibition?which measured 20.5mm?was recorded at a concentration of 250mg/ml. A 50 0mg/ml concentration produced a 23mm zone of inhibition against K. pneumoniae, whereas the control,?gentamycin,?produced a 20mm zone of inhibition. The extract produced a zone of inhibition that measured 23mm against S. pneumoniae at a concentration of 25mg/ml, however, at a concentration of 50 mg/ml, the zone of inhibition only measured 17 mm. A 21.5 mm zone of inhibition was produced against S. pneumoniae at a concentration of 100 mg/ml, and a similar zone was also produced at a concentration of 250 mg/ml. A zone of inhibition against S. pneumoniae at a concentration of 500 mg/ml was 18.5 mm, compared to a 25 mm zone of inhibition produced by the?control?Ciprofloxacin.
The zone of inhibition recorded against E. coli at a concentration of 25mg/ml was 16.5mm, but at a concentration of 50mg/ml, the zone of inhibition produced against E. coli was 18mm.? The extract produced a zone of inhibition that measured 19mm at a concentration?of 100mg/ml E. coli, but at a concentration of 250mg/ml, the zone of inhibition measured 22.5 mm. The zone of inhibition produced against E. coli at a concentration?of 500mg/ml was 21mm, in contrast to the control (Ceftriaxone Sulbactam), which had an 8mm zone of inhibition on the E. coli. The plant extract produced a zone of inhibition that measured 20.5mm at a concentration of 25mg/ml against S. typhi and 21mm at a concentration of 50mg/ml. A zone of inhibition that measured 19.5 mm at a concentration of 100 mg/ml was recorded against S. typhi; however, at a concentration of 250 mg/ml, the zone of inhibition only measured 16.5 mm. In comparison to the control (Levofloxacin), which produced a 25mm zone of inhibition against S. typhi, the 500 mg/ml concentration produced a 20 mm zone of inhibition. From Figure 6, at 25mg/ml concentration, the extract produced a 20.5mm zone of inhibition against S. aureus, whereas a 50mg/ml concentration produced an 18mm zone of inhibition. At 100 mg/ml and 250 mg/ml concentrations, the zones?of inhibition?that measured?15mm and 21 mm respectively in diameter was recorded against S. aureus. The zone of inhibition on S. aureus?at a concentration of 500 mg/ml was measured as?21.5 mm compared to the zone of inhibition produced by?control gentamycin on S. aureus measured at 20mm.
? ? ? ?
? ? ? ? ? ?
? ? ? ?
Figure 6: Activities of n-hexane extracts of J. curcas against S. aureus
DISCUSSION
Result obtained from the various phytochemical constituents present or absent in n-hexane extract of J. curcas is shown in Tables 1. The n-hexane extract of leaves as presented in Table 1 showed the presence of alkaloids, saponins, flavonoids, phenolic content, tannins, reducing sugar and terpenoids with a slight difference with the research of [23] having the presence steroids. In addition to having anti-inflammatory and antioxidant properties, plant compounds called flavonoids also have the ability to scavenge free radicals such hydroxyl radicals, superoxide anions, and lipid peroxyl radicals, which helps in increasing their antioxidant activity[24] Terpenoids are regarded as an anti-cancer and anti-inflammatory agent that is a vital component of both conventional and modern therapy [25]. Quinone is an important component of aerobic metabolism and possesses great anticancer properties [16]. Red blood cells can clump together and precipitate when exposed to saponins. A few properties of saponins include the ability to create foam in aqueous solutions, hemolytic activity, cholesterol-binding capacities, and bitterness [26][27]. Table 2 provides an overview of the antibacterial effects of various J. curcas extracts and a few commercial drugs on the various bacterial strains that were tested in this study. All plant extracts exhibited antibacterial properties, and significant zones of inhibition?(mm)?were observed. Zones of inhibition against the bacterial isolates tested in the study were observed to range from 7.5 to 20.5mm. According to the zone of inhibition, the extract's antibacterial activity is highest against K. pneumoniae (31.5 mm), second against S. pneumoniae (28.5 mm), and third against S. typhi (23.5 mm). the n-hexane extract at 250mg/ml against S. aureus (35.5 mm), K. pneumococcus (26 mm), and E. coli at 250 mg/ml (14.5 mm). Zones of inhibition values demonstrate this extract's medicinal?advantage. The antibacterial properties and therapeutic value of the plant parts of Jatropha curcas have been documented in earlier research [28][29]. Certain phytochemicals, including as saponins, tannins, alkaloids, and glycosides, have been linked to its antibacterial action [30]. Alkaloids, which are abundant in J. curcas, were one of the phytochemical components found in the plant. Alkaloids' toxicity to foreign?organism cells is one of their most prevalent biological characteristics [31]. The potency of J. curcas against both Gram-negative and?Gram-positive?bacteria can be explained by the remarkable effects of alkaloids, one of the biggest classes of phytochemicals found in plants. While this study reports the presence of alkaloids in the n-hexane extract of the leaves, [32] found the lack of alkaloids in J. curcas leaf extracts. ?According to [30] Valdez-Ramirez et al., (2023) J. curcas stem bark aqueous extract has antibacterial action against a variety of bacterial isolates, except Klebsiella pneumonia. In contrast, [33] found that the aqueous leaf extract of J. curcas exhibited no antibacterial action against Proteus sp., S. aureus, P. aeruginosa, or E. coli. However, aqueous extracts of J. curcas (up to 500 mg/ml) showed antibiotic efficacy against P. aeruginosa, E. coli, and K. pneumonia, according to [34]. The discrepancies between the various results might be caused by variations in strains as well as variations in extract concentrations and processing. Within a species, microbial antibiotic sensitivity patterns have been found to vary by strain [30]. The ability of J. curcas' n-hexane extracts to exhibit antibacterial activity against harmful bacterial strains may make the plant a viable option for treating illnesses brought on by these infections.
CONCLUSION
Overall, the results of this study have shown that the leaves of Jatropha curcas contain some phytochemical compounds, such as tannins, alkaloids, and phenolic content, which can bacteriostatically inhibit the growth of the tested pathogenic organisms. However, the leaves of J. curcas can be used in production of drugs.
FUNDING:
This research was funded by Institution Based Research (IBR) intervention 2023 Tertiary Education Trust fund (TETFUND).
ACKNOWLEDGMENTS:
The authors acknowledged the grant given Institution Based Research (IBR) intervention 2023 Tertiary Education Trust fund (TETFUND) and the management of Federal Polytechnic Ayede, Oyo State, Nigeria.
Conflicts of Interest: The authors declare no conflicts of interest
REFERENCE
https://doi.org/10.1016/j.sjbs.2021.02.019.
10.17504/protocols.io.5qpvo3x6dv4o/v1.
https://doi.org/10.1016/j.sjbs.2021.02.019.
10.17504/protocols.io.5qpvo3x6dv4o/v1.






Hb. Bello*, Ka. Odelade, K. Ibrahim, Mo. Adesokan, So. Oluwakemi, Es. Olorunfemi, Comparative Analysis of the Antibacterial Activity of N-Hexane Leaf Extract of Jatropha curcas and Selected Standard Antibiotics Against Bacterial Pathogens, Int. J. Sci. R. Tech., 2025, 2 (2), 33-42. https://doi.org/10.5281/zenodo.14824883
 10.5281/zenodo.14824883
10.5281/zenodo.14824883